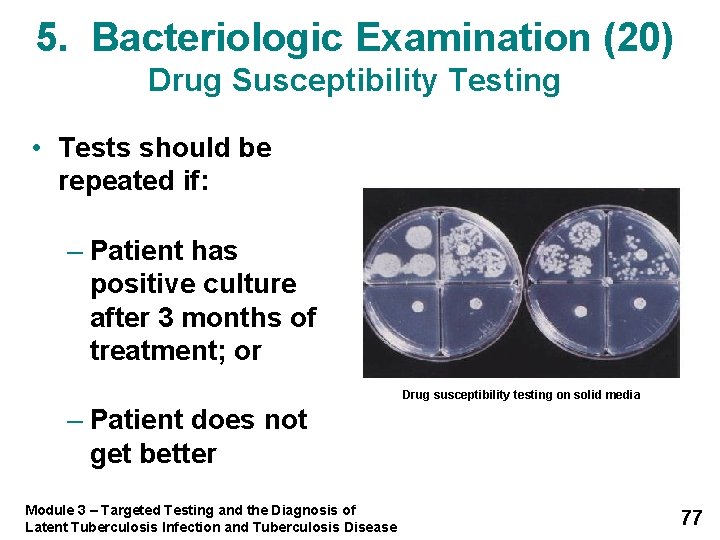
5. Bacteriologic Examination (20) Drug Susceptibility Testing • Tests should be repeated if: –

3 Diagnosis of Latent Tuberculosis Infection and Tuberculosis

3 Diagnosis of Latent Tuberculosis Infection and Tuberculosis Disease 1

Module 3: Objectives At completion of this module, learners will be able to: 1. Identify high-risk groups for targeted testing 2. Describe how to give and interpret a Mantoux tuberculin skin test (TST) and an interferon-gamma release assay (IGRA) 3. Discuss considerations for using either the TST or IGRA for diagnosing infection with M. tuberculosis 4. Describe the components of a medical evaluation for diagnosing TB disease Module 3 – Targeted Testing and the Diagnosis of Latent Tuberculosis Infection and Tuberculosis Disease 2

Targeted Testing 3

Targeted Testing (1) • Targeted testing is a TB control strategy used to identify and treat persons: – At high risk for infection with M. tuberculosis – At high risk for developing TB disease once infected with M. tuberculosis Module 3 – Targeted Testing and the Diagnosis of Latent Tuberculosis Infection and Tuberculosis Disease 4

Targeted Testing (2) • Identifying persons with LTBI is an important goal of TB elimination because LTBI treatment can: – Prevent the development of TB disease – Stop the spread of TB Module 3 – Targeted Testing and the Diagnosis of Latent Tuberculosis Infection and Tuberculosis Disease 5

Targeted Testing (3) High-Risk Groups for TB Infection • Close contacts of people known or suspected to have TB • People who have come within 5 years from areas where TB is common • Low-income groups • People who inject drugs Module 3 – Targeted Testing and the Diagnosis of Latent Tuberculosis Infection and Tuberculosis Disease 6

Targeted Testing (4) High-Risk Groups for TB Infection • People who live or work in high-risk settings • HCWs who serve high-risk clients • Racial or ethnic minority populations • Infants, children, and adolescents exposed to adults in high-risk groups Module 3 – Targeted Testing and the Diagnosis of Latent Tuberculosis Infection and Tuberculosis Disease 7

Targeted Testing (5) High-Risk Groups for TB Disease • People living with HIV • People recently infected with M. tuberculosis (within past 2 years) • People with certain medical conditions known to increase risk for TB • People who inject drugs • Infants and children younger than 4 years old Module 3 – Targeted Testing and the Diagnosis of Latent Tuberculosis Infection and Tuberculosis Disease 8

Diagnosis of Latent TB Infection (LTBI) 9

Diagnosis of LTBI • Available testing methods for M. tuberculosis infection: – Mantoux tuberculin skin test (TST) – Blood tests known as interferon-gamma release assays (IGRAs): • Quanti. FERON®-TB Gold test (QFT-G) • Quanti. FERON®-TB Gold In-Tube (QFT-GIT) • T-SPOT Module 3 – Targeted Testing and the Diagnosis of Latent Tuberculosis Infection and Tuberculosis Disease 10

Mantoux Tuberculin Skin Test (1) • TST is administered by injection • Tuberculin is made from proteins derived from inactive tubercle bacilli • Most people who have TB infection will have a reaction at injection site Module 3 – Targeted Testing and the Diagnosis of Latent Tuberculosis Infection and Tuberculosis Disease Syringe being filled with 0. 1 ml of liquid tuberculin 11

Mantoux Tuberculin Skin Test (2) 0. 1 ml of 5 tuberculin units of liquid tuberculin are injected between the layers of skin on forearm HCW administering Mantoux TST Module 3 – Targeted Testing and the Diagnosis of Latent Tuberculosis Infection and Tuberculosis Disease 12

Mantoux Tuberculin Skin Test (3) • Forearm should be examined within 48 - 72 hours by HCW • Reaction is an area of induration (swelling) around injection site – Induration is measured in millimeters – Erythema (redness) is not measured Module 3 – Targeted Testing and the Diagnosis of Latent Tuberculosis Infection and Tuberculosis Disease Only the induration is measured 13

Mantoux Tuberculin Skin Test (4) Interpreting the Reaction Interpretation of TST reaction depends on size of induration and person’s risk factors for TB Module 3 – Targeted Testing and the Diagnosis of Latent Tuberculosis Infection and Tuberculosis Disease 14

Mantoux Tuberculin Skin Test (5) Interpreting the Reaction • Induration of > 5 mm is considered positive for: – People living with HIV – Recent close contacts of people with infectious TB – People with chest x-ray findings suggestive of previous TB disease – People with organ transplants – Other immunosuppressed patients Module 3 – Targeted Testing and the Diagnosis of Latent Tuberculosis Infection and Tuberculosis Disease 15

Mantoux Tuberculin Skin Test (6) Interpreting the Reaction • Induration of > 10 mm is considered a positive reaction for: – People who have recently come from areas where TB is common – People who inject drugs – People who live or work in high-risk congregate settings – Mycobacteriology laboratory workers Module 3 – Targeted Testing and the Diagnosis of Latent Tuberculosis Infection and Tuberculosis Disease 16

Mantoux Tuberculin Skin Test (7) Interpreting the Reaction • Induration of > 10 mm is considered a positive reaction for: – People with certain medical conditions that increase risk for TB – Children younger than 4 years old – Infants, children, or adolescents exposed to adults in high-risk categories Module 3 – Targeted Testing and the Diagnosis of Latent Tuberculosis Infection and Tuberculosis Disease 17

Mantoux Tuberculin Skin Test (8) Interpreting the Reaction • Induration of > 15 mm is considered a positive reaction for people who have no known risk factors for TB Module 3 – Targeted Testing and the Diagnosis of Latent Tuberculosis Infection and Tuberculosis Disease 18

Diagnosis of Latent TB Infection (LTBI) Mantoux Tuberculin Skin Test Factors that Affect the Reaction 19

Mantoux Tuberculin Skin Test (9) False-Positive Reaction • Factors that can cause people to have a positive reaction even if they do not have TB infection: – Infection with nontuberculous mycobacteria – BCG vaccination – Administration of incorrect antigen – Incorrect measuring or interpretation of TST reaction Module 3 – Targeted Testing and the Diagnosis of Latent Tuberculosis Infection and Tuberculosis Disease 20

Mantoux Tuberculin Skin Test (10) BCG Vaccine • People who have been vaccinated with BCG may have a false-positive TST reaction – However, there is no reliable way to distinguish between reaction caused by TB infection or by BCG vaccine • Individuals should always be further evaluated if they have a positive TST reaction Module 3 – Targeted Testing and the Diagnosis of Latent Tuberculosis Infection and Tuberculosis Disease 21

Mantoux Tuberculin Skin Test (11) False-Negative Reaction • Factors that can cause false-negative reactions: – Anergy – Recent TB infection (within past 8 – 10 weeks) • It can take 2 – 8 weeks after TB infection for body’s immune system to react to tuberculin – Younger than 6 months of age – Recent live-virus (e. g. , measles or smallpox) vaccination – Incorrect method of giving the TST – Incorrect measuring or interpretation of TST reaction Module 3 – Targeted Testing and the Diagnosis of Latent Tuberculosis Infection and Tuberculosis Disease 22

Mantoux Tuberculin Skin Test (12) Any patient with symptoms of TB disease should be evaluated for TB disease, regardless of his or her skin test reaction. Module 3 – Targeted Testing and the Diagnosis of Latent Tuberculosis Infection and Tuberculosis Disease 23

Mantoux Tuberculin Skin Test (13) Anergy • Inability to react to skin tests due to weakened immune system • Anergy testing is no longer routinely recommended Module 3 – Targeted Testing and the Diagnosis of Latent Tuberculosis Infection and Tuberculosis Disease 24

Diagnosis of Latent TB Infection (LTBI) Interferon-Gamma Release Assays (IGRAs) 25

Types of IGRAs • Quanti. FERON®-TB Gold (QFT-G) – CDC guidelines published in 2005 • Quanti. FERON®-TB Gold In-Tube (QFT-GIT) – Approved 10/2007 • T-Spot®. TB test (T-SPOT) – Type of ELISpot assay – Approved 7/2008 T-Spot®. TB test Materials Image Credit: U. S. Food and Drug Administration (FDA), 2009 • CDC guidelines for IGRAs are under development Module 3 – Targeted Testing and the Diagnosis of Latent Tuberculosis Infection and Tuberculosis Disease 26

QFT-G and QFT-GIT (1) • Measures person’s immune reactivity to M. tuberculosis • Used to help diagnose M. tuberculosis infection in persons suspected of having either LTBI or TB disease Module 3 – Targeted Testing and the Diagnosis of Latent Tuberculosis Infection and Tuberculosis Disease 27

QFT-G and QFT-GIT (2) Conducting the Test • Follow manufacturer’s instructions – Confirm arrangements for delivery and testing of blood within 12 hours of collection – Draw sample of blood into tube with heparin – Schedule appointment for patient to receive test results • If needed, medical evaluation and treatment for LTBI or TB disease Module 3 – Targeted Testing and the Diagnosis of Latent Tuberculosis Infection and Tuberculosis Disease 28

QFT-G and QFT-GIT (3) How it Works • Blood samples are mixed with antigens and incubated for 16 - 24 hours • If infected with M. tuberculosis, blood cells will recognize antigens and release interferon gamma (IFN-γ) in response • Results are based on the amount of IFN-γ released in response to antigens and control substances Module 3 – Targeted Testing and the Diagnosis of Latent Tuberculosis Infection and Tuberculosis Disease 29

QFT-G and QFT-GIT (4) Interpreting Results • Test results are based on IFN-γ concentrations • Laboratories can use software provided by manufacturer to calculate results • Results are sent to requesting clinician Module 3 – Targeted Testing and the Diagnosis of Latent Tuberculosis Infection and Tuberculosis Disease Processing QFT-G Sample 30

QFT-G and QFT-GIT (5) Report of Results Result Positive Report/Interpretation M. tuberculosis infection likely M. tuberculosis infection unlikely, but cannot be excluded especially if: Negative Indeterminate 1. Patient has TB signs and symptoms 2. Patient has a high risk for developing TB disease once infected with M. tuberculosis Test did not provide useful information about the likelihood of M. tuberculosis infection. Options are to repeat test, administer a TST, or do no additional testing Module 3 – Targeted Testing and the Diagnosis of Latent Tuberculosis Infection and Tuberculosis Disease 31

T-SPOT • Type of ELISpot assay • Interferon gamma is presented as spots from T cells sensitized to M. tuberculosis • Results are interpreted by subtracting the spot count of the control from the spot count of the sample Module 3 – Targeted Testing and the Diagnosis of Latent Tuberculosis Infection and Tuberculosis Disease 32

IGRA Advantages • Requires single patient visit to conduct test • Results can be available in 24 hours • Does not cause booster phenomenon • Less likely to have incorrect reading of results as compared to TST • BCG vaccination does not affect results Module 3 – Targeted Testing and the Diagnosis of Latent Tuberculosis Infection and Tuberculosis Disease 33

IGRA Disadvantages and Limitations • Blood samples must be processed within 12 hours for some IGRAs • Errors in running and interpreting test can decrease accuracy • Limited data on its use in certain populations • Limited data on its use to determine who is at risk for developing TB disease Module 3 – Targeted Testing and the Diagnosis of Latent Tuberculosis Infection and Tuberculosis Disease 34

Diagnosis of Latent TB Infection (LTBI) TB Testing Programs, the Booster Phenomenon, and Two-Step Testing 35

TB Testing Programs (1) • Many health care facilities have TB testing programs – Employees and residents are periodically given TSTs or IGRAs • Testing programs: – Identify people who have LTBI or TB disease and give them treatment – Determine whether TB is being transmitted in facility Module 3 – Targeted Testing and the Diagnosis of Latent Tuberculosis Infection and Tuberculosis Disease 36

TB Testing Programs (2) Baseline Test • Employees and/or residents are given TSTs or IGRAs when they first enter facility – If person is negative, they may be retested at regular intervals thereafter Module 3 – Targeted Testing and the Diagnosis of Latent Tuberculosis Infection and Tuberculosis Disease 37

TB Testing Programs (3) Conversion • Persons whose TST or IGRA result converts from negative to positive have probably been infected with M. tuberculosis – TST or IGRA conversions may indicate that TB is being transmitted in facility Module 3 – Targeted Testing and the Diagnosis of Latent Tuberculosis Infection and Tuberculosis Disease 38

Booster Phenomenon • Phenomenon in which people who are skin tested many years after they became infected with TB have: – Negative reaction to initial TST – Positive reaction to subsequent TST given up to one year later • Occurs mainly in older adults • May affect accuracy of baseline skin test Module 3 – Targeted Testing and the Diagnosis of Latent Tuberculosis Infection and Tuberculosis Disease 39

Person is infected with M. tuberculosis Figure 3. 4 The booster phenomenon Person is skin tested Person has negative reaction due to decreased ability to react to tuberculin As years pass, person’s ability to react to tuberculin lessens However, this skin test “jogs the memory” of the immune system to recognize and react to tuberculin Person is skin tested again Up to 1 year later (for this example, we assume that the person was NOT exposed to TB during this time) Person has a positive reaction. This is a boosted reaction due to TB infection that occurred a long time ago, not during the time between the two skin tests Module 3 – Targeted Testing and the Diagnosis of Latent Tuberculosis Infection and Tuberculosis Disease 40

Two-Step Testing • Only conducted when TST is used • Distinguishes between boosted reactions and reactions caused by recent infections • Should be used for initial skin testing of persons who will be retested periodically • If person’s initial skin test is negative, they should be given a second test 1 -3 weeks later – Second test positive: probably boosted reaction – Second test negative: considered uninfected Module 3 – Targeted Testing and the Diagnosis of Latent Tuberculosis Infection and Tuberculosis Disease 41

Figure 3. 5 Baseline skin test Two-step testing Reaction Negative Positive Retest 1 -3 weeks later Person probably has TB infection Reaction Negative Positive Person probably does NOT have TB infection Reaction is considered a boosted reaction Repeat at regular intervals; a positive reaction will probably be due to a recent TB infection Retesting not necessary Module 3 – Targeted Testing and the Diagnosis of Latent Tuberculosis Infection and Tuberculosis Disease 42

Diagnosis of TB Disease 43

Medical Evaluation • Components of medical evaluation: 1. 2. 3. 4. 5. Medical history Physical examination Test for TB infection Chest x-ray Bacteriological examination Module 3 – Targeted Testing and the Diagnosis of Latent Tuberculosis Infection and Tuberculosis Disease 44

Diagnosis of TB Disease Medical Evaluation 1. Medical History 2. Physical Examination 3. Test for TB Infection 45

1. Medical History (1) • Clinicians should ask patients if they have: – Symptoms of TB disease – Been exposed to a person with infectious TB or have risk factors for exposure to TB – Any risk factors for developing TB disease – Had LTBI or TB disease before Module 3 – Targeted Testing and the Diagnosis of Latent Tuberculosis Infection and Tuberculosis Disease 46

1. Medical History (2) General Symptoms of TB Disease • Fever • Appetite loss • Chills • Fatigue • Night sweats • Malaise • Weight loss Module 3 – Targeted Testing and the Diagnosis of Latent Tuberculosis Infection and Tuberculosis Disease 47

1. Medical History (3) Symptoms of Pulmonary TB Disease • Cough lasting 3 or more weeks • Chest pain • Coughing up sputum or blood Module 3 – Targeted Testing and the Diagnosis of Latent Tuberculosis Infection and Tuberculosis Disease 48

1. Medical History (4) Symptoms of Extrapulmonary TB Disease • Symptoms of extrapulmonary TB disease depend on part of body that is affected • For example: – TB disease in spine may cause back pain – TB disease in kidneys may cause blood in urine Module 3 – Targeted Testing and the Diagnosis of Latent Tuberculosis Infection and Tuberculosis Disease 49

2. Physical Examination A physical examination cannot confirm or rule out TB disease, but can provide valuable information Module 3 – Targeted Testing and the Diagnosis of Latent Tuberculosis Infection and Tuberculosis Disease 50

3. Test for TB Infection (1) • Types of tests available for diagnosing TB infection in U. S. : – TST – IGRAs • QFT-GIT • T-SPOT Module 3 – Targeted Testing and the Diagnosis of Latent Tuberculosis Infection and Tuberculosis Disease QFT-G lab kit 51

3. Test for TB Infection (2) • Patients with symptoms of TB disease should always be evaluated for TB disease, regardless of their TST or IGRA test result – Clinicians should not wait for TST or IGRA results before starting other diagnostic tests – TST or IGRA should be given at the same time as other steps in the diagnosis of TB disease Module 3 – Targeted Testing and the Diagnosis of Latent Tuberculosis Infection and Tuberculosis Disease 52

Diagnosis of TB Disease Medical Evaluation 4. Chest X-Ray 53

4. Chest X-Ray (1) • When a person has TB disease in lungs, the chest x-ray usually appears abnormal. It may show: – Infiltrates (collections of fluid and cells in lung tissue) – Cavities (hollow spaces within lung) Module 3 – Targeted Testing and the Diagnosis of Latent Tuberculosis Infection and Tuberculosis Disease Abnormal chest x-ray with cavity 54

4. Chest X-Ray (2) • Chest x-rays can: – Help rule out possibility of pulmonary TB disease in persons who have a positive TST or IGRA result – Check for lung abnormalities Module 3 – Targeted Testing and the Diagnosis of Latent Tuberculosis Infection and Tuberculosis Disease 55

4. Chest X-Ray (3) • Chest x-rays cannot confirm TB disease – Other diseases can cause lung abnormalities – Only bacteriologic culture or histology can prove patient has TB disease – Chest x-ray may appear unusual or even appear normal for persons living with HIV Module 3 – Targeted Testing and the Diagnosis of Latent Tuberculosis Infection and Tuberculosis Disease 56

Diagnosis of TB Disease Medical Evaluation 5. Bacteriologic Examination 57

5. Bacteriologic Examination (1) • TB bacteriologic examination is done in a laboratory that specifically deals with M. tuberculosis and other mycobacteria – Clinical specimens (e. g. , sputum and urine) are examined and cultured in laboratory Module 3 – Targeted Testing and the Diagnosis of Latent Tuberculosis Infection and Tuberculosis Disease 58

5. Bacteriologic Examination (2) • Bacteriologic examination has 5 parts – Specimen collection – Examination of acid-fast bacilli (AFB) smears – Direct identification of specimen (nucleic acid amplification) – Specimen culturing and identification – Drug susceptibility testing Module 3 – Targeted Testing and the Diagnosis of Latent Tuberculosis Infection and Tuberculosis Disease 59

5. Bacteriologic Examination (3) Specimen Collection • For pulmonary TB, specimens can be collected by: – Sputum sample – Induced sputum sample – Bronchoscopy TB patient coughing up sputum in a sputum collection booth – Gastric washing Module 3 – Targeted Testing and the Diagnosis of Latent Tuberculosis Infection and Tuberculosis Disease 60

5. Bacteriologic Examination (4) Sputum Sample Specimen Collection • Easiest and least expensive method is to have patient cough into sterile container • HCWs should coach and instruct patient • Should have at least 3 sputum specimens examined – Collected in 8 -24 hour intervals – At least one early morning specimen Module 3 – Targeted Testing and the Diagnosis of Latent Tuberculosis Infection and Tuberculosis Disease 61

5. Bacteriologic Examination (5) Induced Sputum Collection • Induced sputum collection should be used if patient cannot cough up sputum on their own • Patient inhales saline mist, causing deep coughing • Specimen often clear and watery, should be labeled “induced specimen” Module 3 – Targeted Testing and the Diagnosis of Latent Tuberculosis Infection and Tuberculosis Disease 62

5. Bacteriologic Examination (6) Bronchoscopy • Bronchoscopy may be used: – If patient cannot cough up enough sputum – If an induced sputum cannot be obtained • Procedure: instrument is passed through nose or mouth into lung to obtain pulmonary secretions or lung tissue Module 3 – Targeted Testing and the Diagnosis of Latent Tuberculosis Infection and Tuberculosis Disease Bronchoscopy being performed on a patient 63

5. Bacteriologic Examination (7) Gastric Washing • Usually only used if sample cannot be obtained from other procedures • Often used with children • Tube is inserted through nose and into stomach to obtain gastric secretions that may contain sputum Module 3 – Targeted Testing and the Diagnosis of Latent Tuberculosis Infection and Tuberculosis Disease 64

5. Bacteriologic Examination (8) Extrapulmonary TB • Specimens other than sputum may be obtained • Depends on part of body affected • For example: – Urine samples for TB disease of kidneys – Fluid samples from area around spine for TB meningitis Module 3 – Targeted Testing and the Diagnosis of Latent Tuberculosis Infection and Tuberculosis Disease 65

5. Bacteriologic Examination (9) Examination of AFB Smears • Specimens are smeared onto glass slide and stained • AFB are mycobacteria that remain stained after being washed in acid solution Module 3 – Targeted Testing and the Diagnosis of Latent Tuberculosis Infection and Tuberculosis Disease AFB smear 66

5. Bacteriologic Examination (10) Examination of AFB Smears • Number of AFB on smear are counted • According to number of AFB seen, smears are classified as 4+, 3+, 2+, or 1+ – For example, 4+ smear has 10 times as many AFB than 3+ smear • If very few AFB are seen, the smear is classified by the actual number of AFB seen Module 3 – Targeted Testing and the Diagnosis of Latent Tuberculosis Infection and Tuberculosis Disease 67

5. Bacteriologic Examination (11) Examination of AFB Smears Classification of Smear Result Infectiousness of Patient 4+ Strongly positive Probably very infectious 3+ Strongly positive Probably very infectious 2+ Moderately positive Probably infectious 1+ Moderately positive Probably infectious Actual number of AFB seen (no plus sign) Weakly positive Probably infectious No AFB seen Negative May not be infectious Module 3 – Targeted Testing and the Diagnosis of Latent Tuberculosis Infection and Tuberculosis Disease 68

5. Bacteriologic Examination (12) Nucleic Acid Amplification Tests (NAA) • NAA tests directly identify M. tuberculosis from sputum specimens by: – Amplifying (copying) DNA and RNA segments • Can help guide clinician’s decision for patient therapy and isolation • Does not replace need for AFB smear, culture, or clinical judgment Module 3 – Targeted Testing and the Diagnosis of Latent Tuberculosis Infection and Tuberculosis Disease 69

5. Bacteriologic Examination (13) Nucleic Acid Amplification Tests (NAA) • If NAA test and AFB smears are positive: – Patients are presumed to have TB and should begin treatment • If NAA test is negative and AFB smears are positive: – Patients may have nontuberculous mycobacteria infection (NTM) Module 3 – Targeted Testing and the Diagnosis of Latent Tuberculosis Infection and Tuberculosis Disease 70

5. Bacteriologic Examination (14) Culturing and Identifying Specimen • Culturing: – Determines if specimen contains M. tuberculosis – Confirms diagnosis of TB disease Colonies of M. tuberculosis growing on media • All specimens should be cultured Module 3 – Targeted Testing and the Diagnosis of Latent Tuberculosis Infection and Tuberculosis Disease 71

5. Bacteriologic Examination (15) Culturing and Identifying Specimen • Step 1: Detect growth of mycobacteria – Solid media: 3 - 6 weeks – Liquid media: 4 - 14 days • Step 2: Identify organism that has grown – Nucleic acid probes: 2 - 4 hours – Biochemical tests: 6 - 12 weeks Module 3 – Targeted Testing and the Diagnosis of Latent Tuberculosis Infection and Tuberculosis Disease 72

5. Bacteriologic Examination (16) Culturing and Identifying Specimen • Positive culture: M. tuberculosis identified in patient’s culture – Called M. tuberculosis isolate – Confirms diagnosis of TB disease Module 3 – Targeted Testing and the Diagnosis of Latent Tuberculosis Infection and Tuberculosis Disease 73

5. Bacteriologic Examination (17) Culturing and Identifying Specimen • Negative culture: M. tuberculosis NOT identified in patient’s culture – Does not rule out TB disease – Some patients with negative cultures are diagnosed with TB based on signs and symptoms Module 3 – Targeted Testing and the Diagnosis of Latent Tuberculosis Infection and Tuberculosis Disease 74

5. Bacteriologic Examination (18) Culturing and Identifying Specimen • Bacteriological examinations are important for assessing infectiousness and response to treatment • Specimens should be obtained monthly until 2 consecutive cultures are negative • Culture conversion is the most important objective measure of response to treatment Module 3 – Targeted Testing and the Diagnosis of Latent Tuberculosis Infection and Tuberculosis Disease 75

5. Bacteriologic Examination (19) Drug Susceptibility Testing • Conducted when patient is first found to have positive culture for TB • Determines which drugs kill tubercle bacilli • Tubercle bacilli killed by a particular drug are susceptible to that drug • Tubercle bacilli that grow in presence of a particular drug are resistant to that drug Module 3 – Targeted Testing and the Diagnosis of Latent Tuberculosis Infection and Tuberculosis Disease 76
5. Bacteriologic Examination (20) Drug Susceptibility Testing • Tests should be repeated if: – Patient has positive culture after 3 months of treatment; or Drug susceptibility testing on solid media – Patient does not get better Module 3 – Targeted Testing and the Diagnosis of Latent Tuberculosis Infection and Tuberculosis Disease 77

5. Bacteriologic Examination (21) Types of Drug-Resistant TB Mono-resistant Resistant to any one TB treatment drug Poly-resistant Resistant to at least any two TB drugs (but not both isoniazid and rifampin) Multidrugresistant (MDR TB) Resistant to at least isoniazid and rifampin, the two best first-line TB treatment drugs Extensively drug-resistant (XDR TB) Resistant to isoniazid and rifampin, PLUS resistant to any fluoroquinolone AND at least 1 of the 3 injectable second-line drugs (e. g. , amikacin, kanamycin, or capreomycin) Module 3 – Targeted Testing and the Diagnosis of Latent Tuberculosis Infection and Tuberculosis Disease 78

Drug-Resistant TB 79

Drug-Resistant TB (1) • Caused by M. tuberculosis organisms resistant to at least one TB treatment drug – – Isoniazid (INH) (HIN) Rifampin (RIF) Pyrazinamide (PZA) Ethambutol (EMB) • Resistant means drugs can no longer kill the bacteria Module 180 –

Drug-Resistant TB (2) Primary Resistance Caused by person-to-person transmission of drug-resistant organisms Secondary Resistance Develops during TB treatment: • Patient was not given appropriate treatment regimen OR • Patient did not follow treatment regimen as prescribed Module 181 –

Drug-Resistant TB (3) Mono-resistant Resistant to any one TB treatment drug Poly-resistant Resistant to at least any 2 TB drugs (but not both isoniazid and rifampin) Multidrug resistant (MDR TB) Resistant to at least isoniazid and rifampin, the 2 best first-line TB treatment drugs Extensively drug resistant (XDR TB) Resistant to isoniazid and rifampin, PLUS resistant to any fluoroquinolone AND at least 1 of the 3 injectable second-line drugs (e. g. , amikacin, kanamycin, or capreomycin) Module 182 –
- Slides: 82